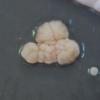
message #65960

11-04-2026 15:45
 Zuzana Sochorová (Egertová)
Zuzana Sochorová (Egertová)
Please, could anyone send me this paper?Moyne G.,

11-04-2026 13:34
Artem PtukhaHello, I am seeking assistance with the identific

11-04-2026 10:19
 Michel Hairaud
Michel Hairaud
Chers amis d'Ascofrance , voici une très bonne no

11-04-2026 10:10
 Michel Hairaud
Michel Hairaud
Dear Ascofrance members, here is some very good ne

10-04-2026 23:22
Gernot FriebesHi,ascospores are 1- to 3-septate, approximately

10-04-2026 15:51
 William Slosse
William Slosse
Hello everyone, On 08/04/26, I found a growth sit

09-04-2026 15:25
Jac GelderblomOn bare soil between mosses Ifound an asco I deter

09-04-2026 13:55
Thomas Læssøehttps://svampe.databasen.org/observations/10589176

09-04-2026 10:12
Thomas Læssøehttps://svampe.databasen.org/observations/10587061

Trying to identify a white mould growing on the surface of glass. Colonies slow-growing, white (magnolia) forming small humps with clefts on PDA, possibly xerophilic (growth temp at 22C = 8mm colonies).
Under the microcope I saw realtively thick curved mycelia but loose and not interwoven, irregular/flexuose, septate, losely branching, 7-9 um thick, rather stout and robust. Conidiphore not numerous, thick, solitary or few branched (x3) very long, swollen at the top, penicillate conidiogenesis apparatus with few(-several) clustered phiaides (?), irregular in length like many fingers. The condiospores seems to be rectangular and of various sizes up to 12um.
I think it is an Aspergillus, but not one I am familiar with.

Aspergillus vitricola and A. tonophilus has been previously isolated from glass, but I don't think they are my specimen. However are there Aspergillus with rectangular spores, shortly catanate? ?
/https://www.jstage.jst.go.jp/article/jplantres1887/75/893/75_893_436/_pdf/-char/en